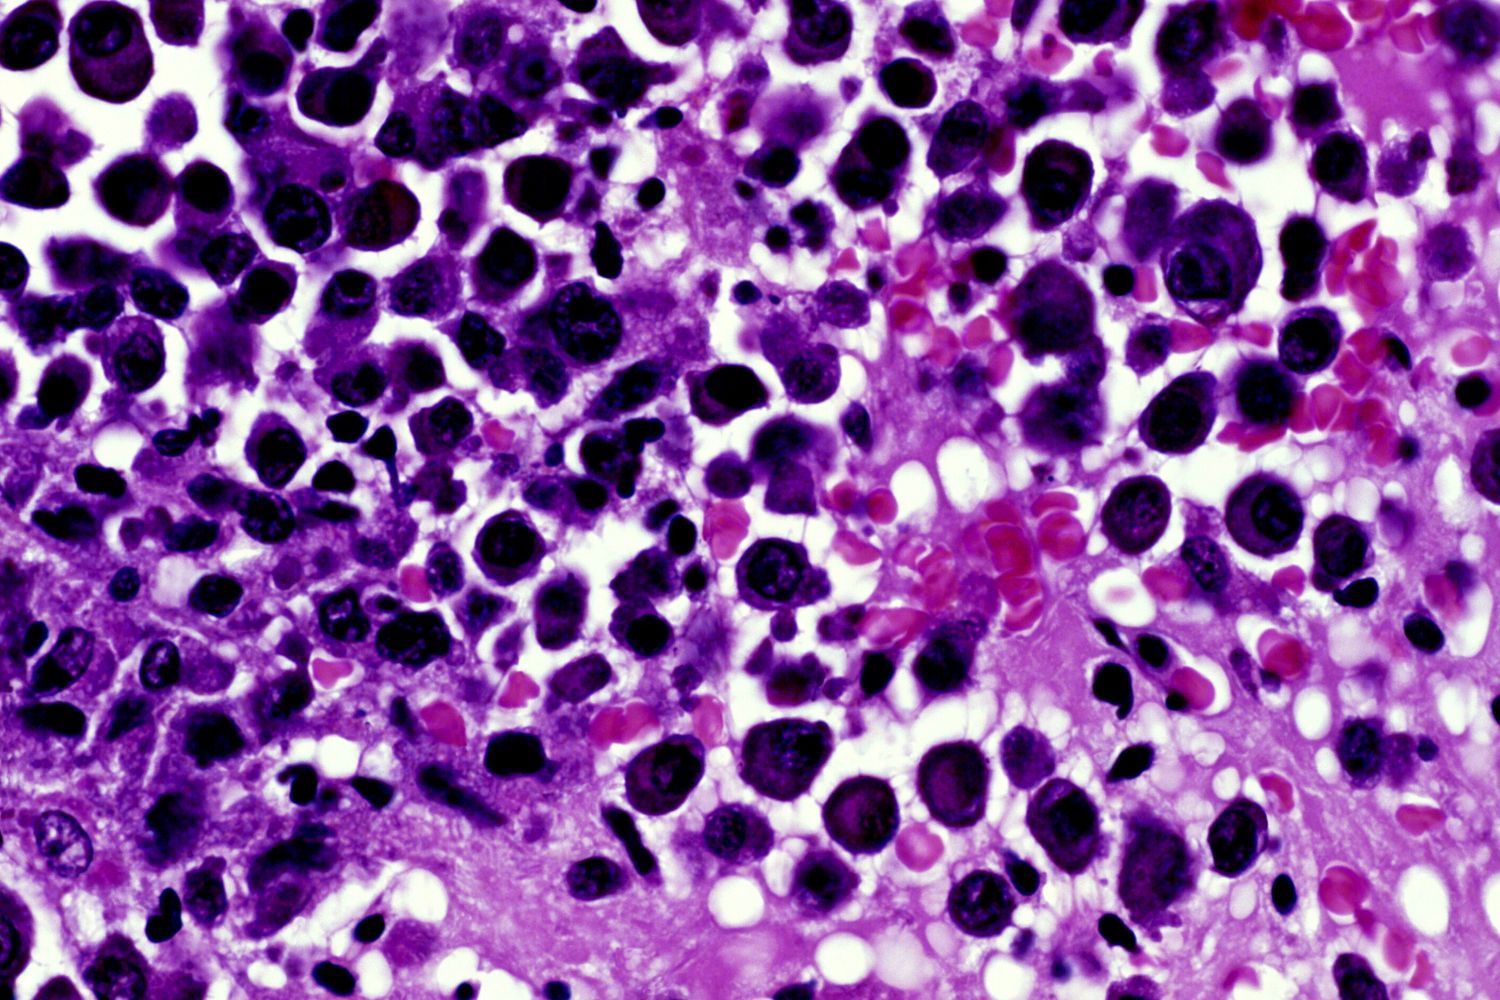
1000x1000

Mieloma multiplo, un tris di farmaci triplica la sopravvivenza

AGI - Oltre due anni in più di sopravvivenza libera da malattia: 36,6 mesi contro i 13,4 della terapia standard e una riduzione del 42% del rischio di decesso, con un follow-up mediano di 39,4 mesi. Sono i risultati emersi dallo studio DREAMM-7, valutati da un comitato di revisione indipendente.
Lo studio, che ha coinvolto 494 pazienti, segna una svolta per chi è affetto da mieloma multiplo, il secondo tumore del sangue per incidenza, con 6.590 nuove diagnosi ogni anno in Italia. Risultati rilevanti anche per lo studio DREAMM-8. Entrambi hanno visto la combinazione di tre farmaci, in due diverse opzioni terapeutiche.
I dati di DREAMM-7 e DREAMM-8 arrivano al congresso della Società Europea di Ematologia (EHA), che si apre oggi a Milano, forti del recente parere positivo del CHMP dell’EMA, che ha raccomandato l'approvazione delle combinazioni con belantamab.
L’autorizzazione è attesa in Europa nel terzo trimestre del 2025. Alla luce di questi risultati, potrebbe essere rivista la strategia terapeutica già dalla prima recidiva, quando cioè è più urgente disporre di opzioni efficaci.
Nel dettaglio, DREAMM-7 ha confrontato la combinazione belantamab mafodotin, bortezomib e desametasone (BVd) con l’attuale standard di cura costituito da daratumumab, bortezomib e desametasone (DVd), in pazienti con mieloma multiplo recidivante o refrattario, già trattati in precedenza.
Anche il DREAMM-8, studio clinico di fase III, multicentrico, in aperto e randomizzato, porta aggiornamenti importanti. In questo caso, si è valutata l’efficacia e la sicurezza della combinazione belantamab mafodotin, pomalidomide e desametasone (BPd) rispetto al regime con bortezomib, pomalidomide e desametasone (PVd).
I 302 partecipanti erano tutti già esposti a lenalidomide, molti dei quali refrattari. "Nel DREAMM-8 abbiamo osservato un miglioramento statisticamente e clinicamente significativo della cosiddetta progression free survival", spiega Alessandro Corso, direttore della Struttura Complessa di Ematologia e del Dipartimento di Oncologia dell'Ospedale di Legnano - ASST Ovest Milanese.
A un follow-up mediano di 28 mesi, la sopravvivenza libera da progressione ha raggiunto 32,6 mesi nel gruppo BPd rispetto ai 12,5 mesi del gruppo PVd. Dopo un anno, l’80% dei pazienti trattati con BPd era vivo e senza progressione di malattia, contro il 67% del gruppo di controllo.
Un ulteriore vantaggio non trascurabile: belantamab mafodotin può essere somministrato in regime ambulatoriale, senza necessità di pre-medicazione o ospedalizzazione.
"I risultati di DREAMM-7 – precisa Corso – mostrano come belantamab mafodotin in combinazione con BorDex rappresenti un miglioramento significativo rispetto al regime a base di daratumumab in seconda linea, anche in pazienti refrattari alla lenalidomide, ampiamente usata in prima linea.
DREAMM-8 mostra invece efficacia in pazienti ancora più complessi, refrattari sia a lenalidomide che a daratumumab. Le terapie anti-BCMA stanno contribuendo a migliorare la sopravvivenza dei pazienti con mieloma multiplo. In particolare, belantamab mafodotin offre anche il vantaggio di una somministrazione in Day Hospital, accessibile anche in centri ospedalieri periferici.